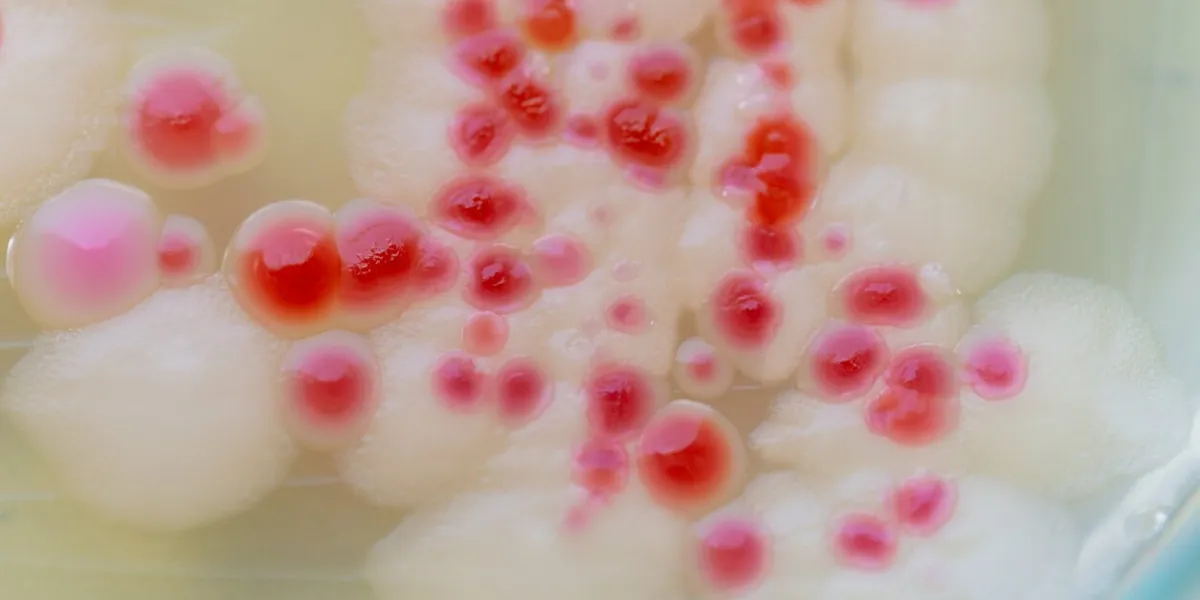

Pourquoi ces traces roses dans la salle de bain doivent vous alerter
Serratia marcescens, vous connaissez ? Cette bactérie laisse des traces roses qui “ressemblent à du vomi”. Du moins est-ce ainsi que le présente le Dr Rajan Karan, un médecin britannique très actif sur les réseaux sociaux. Dans l’une de ses vidéos mises en ligne sur le réseau TikTok, le chirurgien met en garde contre ces substances gélatineuses. Ce sont en réalité des bactéries qui, précise-t-il :
“vomissent du rose pétant partout dans votre salle de bain” et apprécient particulièrement les “lieux humides et moites” et “grignoter les dépôts gras comme ceux que l’on trouve dans les savons et les shampoings d’où leur goût pour vos salles de bain embuées.”
Ce qui leur donne cette couleur rose
Cette bactérie, appelée en latin Serracia Marcescens appartient à la famille des entérobactéries, comme le précise une fiche mise en ligne par le service de santé publique nationale du Canada : “Omniprésentes dans le sol, l’eau et à la surface des plantes”, ces bactéries “produisent un pigment rouge à rose, appelé prodigiosine.
Traces roses : Les risques pour la santé
Ces bactéries peuvent induire plusieurs types d’infection. Elles sont le plus souvent associées à des infections nosocomiales (celles qui sont contractées lors d’un séjour dans un établissement de santé) telles que :
- les Infections urinaires
- les broncho-pneumopathies
- des bactériémies
- des Infections des voies biliaires
- des surinfections de plaies.
Elles peuvent en effet coloniser des dispositifs médicaux, comme des cathéters ou des sondes urinaires, augmentant ainsi le risque de complications graves.
Toutefois, si ces bactéries prolifèrent chez vous, il est aussi possible de contracter une infection, surtout si elles entrent en contact avec une plaie ouverte. Chez les personnes les plus à risque (immunodéprimées), cela peut provoquer des situations graves. En cas de doute, contactez rapidement un professionnel ou une professionelle de santé.
Ce qu’il faut faire si vous voyez ces moisissures roses
Bien sûr, si vous voyez cette moisissure chez vous, n’y touchez pas à mains nues. Avec des gants, et un désinfectant, nettoyez soigneusement les zones concernées, ainsi que l’ensemble des lieux les plus humides chez vous. Cela vaut également pour les autres types de moisissures qui peuvent engendrer des infections respiratoires.
Il est recommandé d’utiliser un désinfectant à base d’eau de Javel ou un produit antifongique spécifique pour garantir l’élimination complète des bactéries.
Enfin en prévention, pensez à ventiler régulièrement vos pièces d’eau et à essuyer les surfaces après chaque utilisation pour limiter l’accumulation d’humidité.
